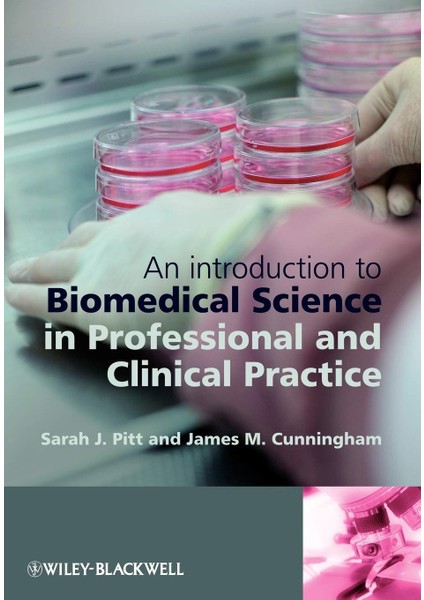

Wiley An Introduction To Biomedical Science In Professional And Clinical Practice
Henüz değerlendirilmemişİlk sen değerlendir
Satıcı: Toy Fox
9,3
9,3Satıcı puanı
Satıcı puanı, müşteri geri bildirimleri ve satıcının sipariş sürecindeki performansı dikkate alınarak hesaplanmaktadır.Ürün Bilgileri
Yayın Tarihi
2009
Cilt Durumu
Ciltsiz
Basım Dili
İngilizce
Boyut
Normal Boy
An Introduction To Biomedical Science In Professional And Clinical Practice
Sayfa Sayısı: 240 Kitabın Dili: İngilizce Cilt Durumu: CiltsizÜrün özellikleri
Yayın Tarihi
2009
Cilt Durumu
Ciltsiz
Basım Dili
İngilizce
Boyut
Normal Boy
Yazar
Sarah J Pitt
Sayfa Sayısı
240
Stok Adedi
5 adetten az
Diğer
Yurt Dışı Satış
Yok
Stok Kodu
HBCV0000CHWL4J
Hatalı içerik bildir
Popüler Aramalar